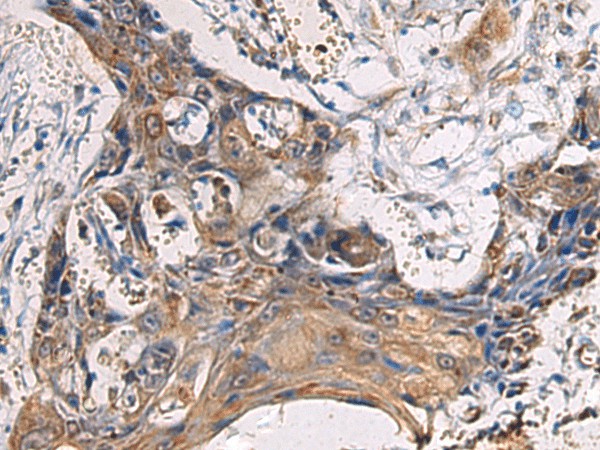
Валидация Elabscience E-AB-53171

| UNIPROT | O60759 |
| Иммуноген | Гибридный белок, соответствующий человеческому CYTIP |
CYTIP Polyclonal Antibody (E-AB-53171)
Реактивность подтвержденная:
человек, мышь, крыса
Источник (хозяин):
кролик
Валидировано для:
IHC
Характеристики
Техническое описание
| Каталожный номер | E-AB-53171 |
| Название антигена | Cytohesin Interacting Protein (CYTIP) |
| UNIPROT | O60759 |
| Иммуноген | Гибридный белок, соответствующий человеческому CYTIP |
| Английские синонимы | CASP, HE, B3-1, CYBR, PSCDBP, CYTHIP, Pleckstrin Homology,Sec7 And Coiled-Coil Domains,Binding, Cytohesin binder and regulator, Cytohesin-associated scaffolding protein |
Реактивность подтвержденная Нужна другая реактивность? |
человек, мышь, крыса |
| Источник (хозяин) | кролик |
| Изотип | IgG |
| Клональность | поликлональное |
| Рекомбинантное | нет |
| Готовое к использованию | нет |
| Концентрация | 1.5 мг/мл |
| Конъюгат | нет |
| Валидировано для | IHC Иммуногистохимия |
| Рекомендуемые разведения | IHC 1:100-1:300 |
| Метод очистки | Аффинная очистка с антигеном |
| Состав буфера | PBS с 0.05% NaN3 и 40% глицерин,pH7.4 |
| Условия доставки | термобокс с аккумуляторами холода |
| Условия хранения | Хранить при -20°C - 12 месяцев. Избегать повторяющихся циклов замораживания/оттаивания |
| Срок хранения | 12 месяцев |
| Производитель | Elabscience |
| Ссылка на страницу товара на сайте производителя | https://www.elabscience.com/p-cytip_polyclonal_antibody-e_ab_53171 |
|
Артикул
|
Наименование |
Производитель
|
|---|
Акции и предложения
Популярные продукты:
Monoclonal Antibody to Enolase 1 (ENO1) (MAB449Hu24)
Источник (хозяин): мышь
Реактивность подтвержденная: человек
Валидировано для: WB
Реактивность подтвержденная: человек
Валидировано для: WB
Chicken GA-binding protein alpha chain ELISA kit (E12G0709)
Организм: курица
Bovine GA-binding protein alpha chain ELISA kit (E11G0709)
Организм: корова
Monkey GA-binding protein alpha chain ELISA kit (E09G0709)
Организм: обезьяна
Human A kinase anchor protein 4(AKAP4) ELISA kit (E01A1357)
Организм: человек
Диапазон определения: 100-2500 пг/мл
Чувствительность: 1 пг/мл
Диапазон определения: 100-2500 пг/мл
Чувствительность: 1 пг/мл